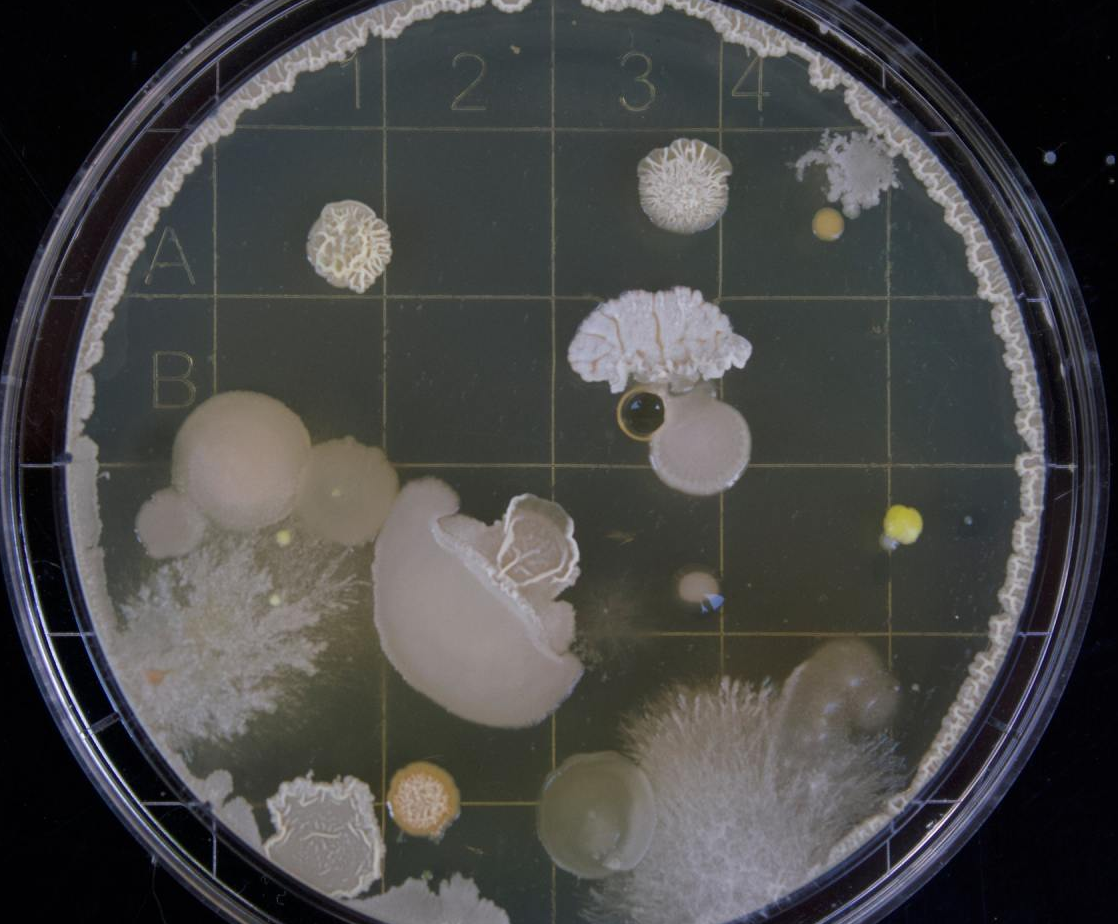
Petri dish with various bacterial colonies, white, yellow, and beige, growing on agar.

Conditions We Treat
We treat all gastrointestinal related conditions. Please click on the tab below to learn more. Scroll below to learn about the services we provide.

Procedures
Upper endoscopy is a procedure used to visually examine your upper digestive system with a tiny camera on the end of a long, flexible tube.
Colonoscopy is a careful viewing of the lining of the colon on a high definition video monitor performed by insertion of a thin flexible tube with a tiny video camera on its tip while the patient is asleep or deeply sedated.
Endoscopic Retrograde Cholangiopancreatography (ERCP) is a common investigative procedure that uses a long, slender and flexible tube to view from the mouth to the duodenum.
Flexible sigmoidoscopy is an exam used to evaluate the lower part of the large intestine (colon). During the exam, a thin, flexible tube is inserted into the rectum.
Hemorrhoid banding, also called rubber band ligation, is a treatment method for hemorrhoids that don’t respond to home treatments. It’s a minimally invasive technique that involves tying the base of the hemorrhoid with a rubber band to stop blood flow to the hemorrhoid.
Small intestinal bacterial overgrowth (SIBO) is a condition affecting the small intestine that causes pain and diarrhea. A breath test is a common test for diagnosing SIBO.
The hydrogen breath test is a method used to diagnose lactose intolerance or determine if abnormal bacteria are present in the colon.
We refer you to comprehensive counseling available on proper nutrition and weight management.